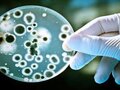
Đáp án bài 1 trang 68 sgk sinh học 9

Trả lời câu hỏi bài 3 trang 68 SGK sinh lớp 9
Xem ngay hướng dẫn cách làm và đáp án bài 3 trang 68 sách giáo khoa sinh học lớp 9 để biết hậu quả của biến đổi số lượng ở từng cặp NST như thế nào
Soạn sinh học 9 bài 23 đột biến số lượng nhiễm sắc thể giúp bạn ôn tập kiến thức và trả lời tốt các câu hỏi bài tập trang 68 SGK Sinh học 9.

Những tài liệu hướng dẫn sinh 9 bài 23 được Đọc Tài Liệu biên soạn giúp bạn trả lời tốt các câu hỏi sách giáo khoa và nắm vững các kiến thức về Đột biến số lượng nhiễm sắc thể đã được học
Tham khảo nagay...
1. Đột biến thêm hoặc mất một NST ở một cặp NST nào đó có thể xảy ra ở người, động vật và thực vật.
2. Các đột biến này thường do không phân li của một cặp NST trong giảm phân, dẫn đến tạo thành giao tử có 2 NST hoặc không có NST nào của cặp NST tương đồng nào đó.

Xem ngay hướng dẫn cách làm và đáp án bài 3 trang 68 sách giáo khoa sinh học lớp 9 để biết hậu quả của biến đổi số lượng ở từng cặp NST như thế nào

Hướng dẫn giải bài tập và đáp án bài 2 trang 68 SGK sinh học lớp 9
Xem cách làm và đáp án bài 1 trang 68 SGK sinh học lớp 9 để biết được sự biển đổi số lượng ở một cặp NST thường thấy ở những dạng nào

Quan sát hình 23.1 để trả lời câu hỏi thảo luận trang 67 sgk sinh học lớp 9